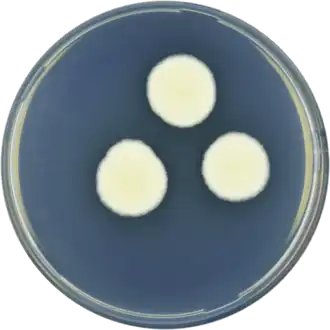

Аспергилл белоснежный
| Аспергилл белоснежный | ||||||||||
|---|---|---|---|---|---|---|---|---|---|---|
| ||||||||||
| Научная классификация | ||||||||||
|
Домен: Царство: Подцарство: Отдел: Подотдел: Класс: Подкласс: Eurotiomycetidae Порядок: Семейство: Aspergillaceae Род: Секция: Candidi Вид: Аспергилл белоснежный |
||||||||||
| Международное научное название | ||||||||||
| Aspergillus candidus Link, 1809 | ||||||||||
| ||||||||||
Асперги́лл белосне́жный (лат. Aspergíllus cándidus) — вид несовершенных грибов (телеоморфная стадия неизвестна), относящийся к роду Аспергилл (Aspergillus).
Описание
Колонии на агаре Чапека с дрожжевым экстрактом (CYA) 1,5—2 см в диаметре на 7-е сутки, зернистые до шерстистых, с белым мицелием и обильным белым конидиальным спороношением. Реверс бледный или жёлто-оранжевый. При 37 °C колонии 2—2,5 см в диаметре, иногда более крупные. На агаре с солодовым экстрактом (MEA) колонии 1—2,5 см в диаметре на 7-е сутки, с тускло-коричневым реверсом.
Конидиеносные головки двухъярусные, с гладкой или шероховатой ножкой 200—500 мкм и более длиной, с обычно шаровидным апикальным вздутием до 10—40 мкм и более. Метулы покрывающие всю поверхность вздутия, 15—20 мкм длиной. Фиалиды 5—9 мкм длиной. Конидии в основном шаровидные, гладкие, 2,5—3,5 мкм в диаметре.
Отличия от близких видов
Определяется по чисто-белому конидиальному спороношению. От Aspergillus niveus отличается образованием метул свыше 10 мкм длиной по всей поверхности апикального вздутия конидиеносца.
Экология
Ксерофильный вид, часто выделяемый из почвы и с различных растительных субстратов, в том числе с пищевых продуктов и с зерна, с различных орехов, арахиса, бобов, семян подсолнечника.
Продуцент койевой кислоты.
Таксономия
Aspergillus candidus Link, Mag. Ges. Naturf. Fr. Berl. 3(1): 16 (1809).
Литература
- Pitt J. I., Hocking A. D. Fungi and Food Spoilage. — Springer, 2009. — P. 297—299. — ISBN 978-0-387-92206-5. — doi:10.1007/978-0-387-92207-2.
- Пидопличко Н. М. Грибы-паразиты культурных растений. — Киев: Наукова думка, 1977. — Т. 2. — С. 47.